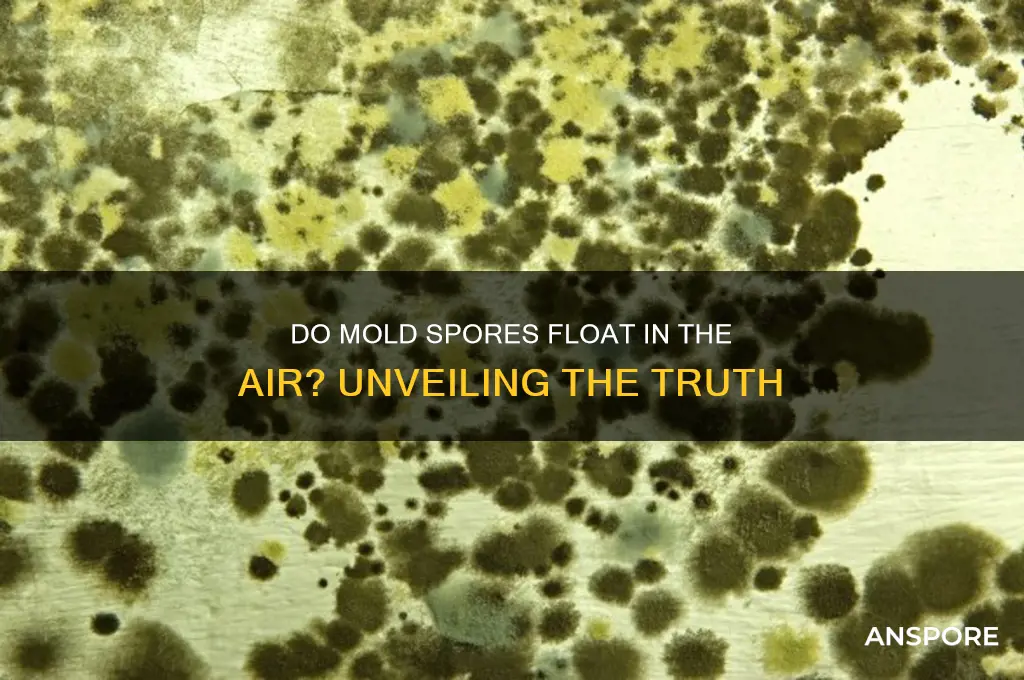
do mold spores float in the air

Mold spores are microscopic particles that are naturally present in the environment, both indoors and outdoors. These lightweight, resilient structures are produced by mold fungi as part of their reproductive process and are easily dispersed through the air. Due to their small size and low weight, mold spores can float in the air for extended periods, allowing them to travel significant distances and settle on various surfaces. This airborne nature makes them a common indoor and outdoor air pollutant, potentially leading to health issues for individuals with allergies, asthma, or compromised immune systems. Understanding whether mold spores float in the air is crucial for assessing their impact on indoor air quality and implementing effective prevention and remediation strategies.
| Characteristics | Values |
|---|---|
| Size | Typically 2-10 microns in diameter, small enough to remain airborne for extended periods. |
| Weight | Extremely lightweight, allowing them to float and travel through air currents. |
| Airborne Capability | Yes, mold spores are naturally airborne and can be carried over long distances. |
| Survival in Air | Can survive in the air for days to weeks, depending on environmental conditions. |
| Concentration | Varies widely; outdoor air typically contains 100-1,000 spores per cubic meter, while indoor air can have higher concentrations in mold-prone areas. |
| Visibility | Invisible to the naked eye due to their microscopic size. |
| Health Impact | Can cause allergic reactions, respiratory issues, and other health problems when inhaled in large quantities. |
| Environmental Factors | Affected by humidity, temperature, and air movement, which influence their dispersal and survival. |
| Settling | Eventually settle on surfaces but can be re-suspended into the air by disturbances like airflow or human activity. |
| Detection | Detected through air sampling or spore traps, often used in mold inspections. |
Explore related products
What You'll Learn

Mold spore size and weight
Mold spores are remarkably small, typically measuring between 2 to 100 micrometers in size. To put this into perspective, a human hair averages about 75 micrometers in diameter, meaning many mold spores are invisible to the naked eye. This minuscule size is a critical factor in their ability to float in the air, as it allows them to remain suspended for extended periods. Their lightweight nature, often weighing less than a trillionth of a gram, further enables them to travel on air currents, dispersing widely and infiltrating even the smallest spaces.
Consider the practical implications of this size and weight. When mold grows indoors, its spores can easily become airborne during routine activities like vacuuming, opening windows, or even walking on carpeted floors. These spores can then circulate through HVAC systems, spreading to other areas of a building. For individuals with allergies or respiratory conditions, this dispersion can trigger symptoms such as sneezing, coughing, or asthma attacks. Understanding the dimensions of mold spores underscores the importance of proper ventilation and air filtration systems in maintaining indoor air quality.
A comparative analysis reveals that mold spores are not unique in their ability to float due to size and weight; pollen and dust particles share similar characteristics. However, mold spores differ in their resilience and adaptability. They can survive in a variety of environments, from dry surfaces to damp corners, and remain dormant for years until conditions are favorable for growth. This durability, combined with their small size, makes them particularly challenging to eradicate once they become airborne. Unlike larger particles that settle quickly, mold spores can remain aloft for days, increasing the likelihood of inhalation or deposition on surfaces.
To mitigate the risks associated with airborne mold spores, specific steps can be taken. Regularly cleaning and replacing air filters in HVAC systems can trap spores before they circulate. Using HEPA (High-Efficiency Particulate Air) filters in vacuum cleaners and air purifiers can capture particles as small as 0.3 micrometers, effectively reducing spore counts. In areas prone to moisture, such as bathrooms and basements, maintaining humidity levels below 60% and promptly addressing leaks can prevent mold growth at its source. For those with sensitivities, wearing masks during activities that disturb surfaces can provide an additional layer of protection.
In conclusion, the size and weight of mold spores are fundamental to their airborne nature, enabling widespread dispersal and posing health risks, particularly in enclosed spaces. By understanding these characteristics, individuals can implement targeted strategies to minimize exposure and maintain healthier indoor environments. Whether through improved ventilation, filtration, or moisture control, proactive measures can significantly reduce the impact of these microscopic particles.
Can Mold Spores Survive in Cold Temperatures? The Chilling Truth
You may want to see also

Airborne mold spore movement
Mold spores are microscopic, lightweight particles designed for dispersal, and their primary mode of travel is through the air. These spores, ranging in size from 2 to 100 microns, are easily lifted by air currents, both indoors and outdoors. Their small size and low density allow them to remain suspended for extended periods, sometimes traveling miles before settling. This natural mechanism ensures mold’s survival and propagation, but it also poses health risks when spores infiltrate indoor spaces. Understanding how mold spores move through the air is crucial for mitigating their presence and potential harm.
To reduce airborne mold spores, practical steps can be taken. Regularly cleaning air filters in HVAC systems ensures they capture spores effectively instead of recirculating them. Using HEPA air purifiers in high-risk areas, such as basements or bathrooms, can significantly decrease spore counts. Keeping indoor humidity below 50% with dehumidifiers discourages mold growth and spore release. Additionally, avoiding carpet in damp-prone areas and promptly addressing water leaks can prevent mold colonies from forming and releasing spores into the air.
Comparing indoor and outdoor spore movement reveals distinct challenges. Outdoors, spores disperse widely, diluting their concentration and reducing health risks. Indoors, however, confined spaces allow spores to accumulate, particularly in areas with limited airflow. This concentration increases exposure, especially for individuals with allergies, asthma, or compromised immune systems. While outdoor spores are inevitable, indoor management strategies can drastically reduce their impact, emphasizing the need for proactive measures in homes and workplaces.
The movement of mold spores through the air is not just a biological phenomenon but a practical concern for health and comfort. By understanding the factors driving spore dispersal and implementing targeted interventions, individuals can create environments less hospitable to mold. From optimizing ventilation to using air purifiers, these actions collectively reduce airborne spore counts, safeguarding indoor air quality. Awareness and action are key to controlling this invisible yet pervasive issue.
Do Milky Spores Survive in Granular Bags? Uncovering the Truth
You may want to see also

Factors affecting spore floatation
Mold spores are remarkably lightweight, typically measuring between 3 and 100 microns in size, which allows them to remain suspended in the air for extended periods. This buoyancy is a key factor in their dispersal, enabling them to travel vast distances and colonize new environments. However, not all spores float equally, and several factors influence their ability to stay airborne. Understanding these factors is crucial for managing indoor air quality and preventing mold growth.
Spore Size and Shape: The Foundation of Floatation
Smaller spores, such as those from *Aspergillus* (2–3 microns), float more easily than larger ones like *Stachybotrys* (10–20 microns). Shape also plays a role; spherical or smooth-walled spores experience less air resistance, enhancing their floatation. For instance, *Cladosporium* spores, with their compact, rounded structure, are among the most common airborne molds due to their aerodynamic efficiency. Conversely, spores with rough surfaces or irregular shapes may settle more quickly, reducing their airborne lifespan.
Environmental Conditions: The Role of Air Movement and Humidity
Air currents are a primary driver of spore floatation. Indoor environments with poor ventilation or stagnant air can trap spores, increasing their concentration. Conversely, fans, HVAC systems, or even opening windows can disperse spores more widely. Humidity levels also matter; spores absorb moisture, increasing their weight and reducing floatation. In environments with relative humidity above 60%, spores may become too heavy to remain airborne, settling on surfaces instead. Practical tip: maintain indoor humidity below 50% to minimize spore floatation and growth.
Surface Interactions: When Spores Settle
While floatation is essential for dispersal, spores eventually settle due to gravity or surface attraction. Electrostatic charges on surfaces, such as carpets or upholstery, can attract spores, pulling them out of the air. This is why regular cleaning of these materials is critical in mold-prone areas. Additionally, surfaces with high moisture content, like damp walls or leaky ceilings, provide ideal conditions for spore germination, ending their airborne phase.
Biological Factors: Spore Viability and Release Mechanisms
Not all spores are released simultaneously or with equal force. Mold colonies release spores in response to environmental cues, such as light, temperature, or nutrient depletion. For example, *Penicillium* spores are often released in dry, windy conditions, maximizing their floatation potential. Moreover, the viability of spores affects their behavior; damaged or dormant spores may settle more quickly due to altered structures. Monitoring these biological triggers can help predict spore release and floatation patterns, aiding in proactive mold control.
By addressing these factors—spore size, environmental conditions, surface interactions, and biological triggers—individuals can better manage airborne mold spores. Whether through humidity control, improved ventilation, or targeted cleaning, understanding these dynamics empowers effective prevention and mitigation strategies.
Are Fungal Spores Dangerous? Unveiling Health Risks and Safety Tips
You may want to see also
Explore related products

Mold spore detection methods
Mold spores are ubiquitous in the air, and their detection is crucial for maintaining indoor air quality and preventing health issues. One of the most common methods for detecting airborne mold spores is air sampling, which involves collecting air samples using specialized equipment. Devices like air-o-cells, spore traps, or impactors draw in a measured volume of air, capturing spores on a collection medium such as a slide or adhesive surface. These samples are then analyzed under a microscope to identify and quantify spore types. For instance, a typical air sampling protocol might involve collecting 75 liters of air per sample in residential settings, following guidelines from organizations like the EPA or AIHA. This method is highly effective for identifying specific mold genera and assessing spore concentrations, making it a cornerstone of mold investigations.
Another detection method gaining popularity is real-time particle counting, which uses laser-based particle counters to measure particulate matter in the air, including mold spores. While these devices cannot differentiate between mold spores and other particles, they provide immediate data on airborne particle levels, allowing for quick assessments of air quality. For example, a sudden spike in particle counts in a specific area might indicate a mold source, prompting further investigation. This method is particularly useful for initial screenings or monitoring changes in air quality over time, though it should be complemented with other techniques for definitive identification.
For those seeking a more accessible and cost-effective approach, DIY mold test kits are widely available. These kits typically include adhesive lifts, swabs, or petri dishes for collecting samples, which are then sent to a lab for analysis. While convenient, these kits have limitations. For instance, surface sampling may not accurately reflect airborne spore levels, and improper collection techniques can lead to false results. Users should follow instructions carefully, such as avoiding sampling during or immediately after cleaning, as this can disturb spores and skew results. Despite their drawbacks, these kits can serve as a preliminary tool for homeowners to identify potential mold issues before consulting professionals.
Advanced detection methods, such as PCR (polymerase chain reaction) analysis, offer unparalleled precision in identifying mold species. By amplifying and analyzing DNA from collected samples, PCR can detect even low concentrations of specific mold types, including those that are non-viable or difficult to culture. This method is particularly valuable in healthcare or research settings where accurate identification of pathogenic molds is critical. However, it is more expensive and time-consuming than traditional methods, requiring specialized equipment and expertise. For most residential or commercial applications, a combination of air sampling and microscopy remains the practical standard, balancing accuracy and feasibility.
In conclusion, the choice of mold spore detection method depends on the specific needs and context of the investigation. Air sampling and microscopy provide detailed, quantifiable data, while real-time particle counting offers immediate insights. DIY kits are accessible but require careful use, and PCR analysis delivers unmatched precision for specialized cases. By understanding these methods and their applications, individuals and professionals can effectively detect and address airborne mold spores, ensuring healthier indoor environments.
Are White Mold Spores Common? Uncovering the Truth About Mold Colors
You may want to see also

Health risks of airborne spores
Mold spores are ubiquitous in the air, with estimates suggesting that we inhale thousands daily without harm. However, prolonged exposure to elevated concentrations can trigger adverse health effects, particularly in susceptible individuals. The risk lies in the body’s response to these foreign particles rather than the spores themselves. When inhaled, mold spores can provoke allergic reactions, inflammation, or infections, depending on the individual’s immune system and the spore type. For instance, *Aspergillus* spores can cause aspergillosis, a serious lung infection, while *Stachybotrys* (black mold) spores are linked to mycotoxin exposure, though evidence of severe toxicity in humans remains limited.
Children, the elderly, and immunocompromised individuals are most vulnerable to airborne spore-related health risks. In children, repeated exposure to mold spores has been associated with the development of asthma, with studies showing a 30-50% increased risk in mold-infested homes. The elderly, often with weakened immune systems, may experience exacerbated respiratory conditions like chronic obstructive pulmonary disease (COPD). Immunocompromised individuals, such as those undergoing chemotherapy or living with HIV, face heightened risks of fungal infections, as their bodies struggle to combat invasive spore colonization.
Practical steps can mitigate these risks. Maintaining indoor humidity below 60% discourages mold growth, while regular cleaning of HVAC systems prevents spore circulation. HEPA air purifiers can reduce airborne spore counts, particularly in high-risk areas like basements. For those with allergies or asthma, monitoring local mold spore counts (often included in weather forecasts) can help plan outdoor activities. If symptoms like persistent coughing, sneezing, or skin irritation arise, consult a healthcare provider for targeted treatments, such as antifungal medications or immunotherapy.
Comparatively, the health risks of airborne mold spores are often overshadowed by concerns about visible mold growth, yet spores pose a more insidious threat due to their invisibility. Unlike surface mold, which can be scrubbed away, spores require proactive air quality management. For example, while surface mold in a bathroom may cause cosmetic issues, airborne spores from hidden mold in walls can lead to chronic respiratory problems. This distinction highlights the importance of addressing both visible and invisible mold sources to safeguard health.
In conclusion, while mold spores are an unavoidable part of the environment, their health risks are manageable through awareness and action. By understanding the specific vulnerabilities of different age groups and health conditions, individuals can take targeted steps to reduce exposure. Whether through environmental controls, medical interventions, or behavioral adjustments, minimizing airborne spore inhalation is key to preventing associated health complications.
Are Psilocybin Spores Legal to Sell? Understanding the Laws
You may want to see also
Frequently asked questions
Yes, mold spores are lightweight and can easily float in the air, allowing them to travel and spread to new locations.
Mold spores can remain airborne indefinitely, depending on air currents, humidity, and other environmental factors.
Yes, inhaling airborne mold spores can trigger allergies, asthma, respiratory issues, and other health problems, especially in sensitive individuals.
Yes, mold spores are naturally present in both indoor and outdoor air, but their concentration increases in damp or mold-infested environments.
Yes, high-efficiency particulate air (HEPA) purifiers can effectively capture and remove airborne mold spores, improving indoor air quality.

























